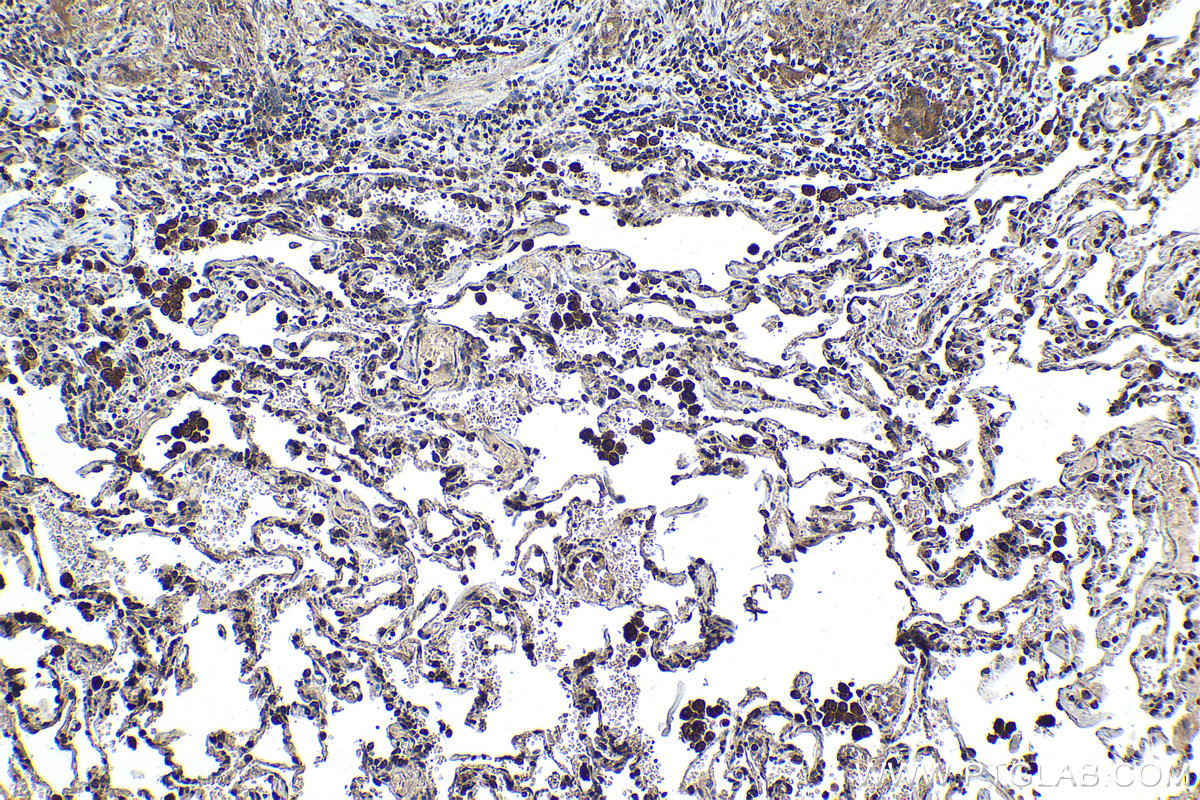

IHCeasy® PHF1 Ready-To-Use IHC Kit
PHF1 Ready-to-use reagent kit for IHC.
Reactivity
Human, Mouse, Rat
Sample Type
FFPE tissue
Cat no : KHC1450
Synonyms
hPCl1, MTF2L2, PCL1, PHD finger protein 1, PHF1, PHF2, Polycomb like protein 1, Protein PHF1
Validation Data Gallery
Product Information
KHC1450 is a ready-to-use IHC kit for staining of PHF1. The kit provides all reagents, from antigen retrieval to cover slip mounting, that require little to no diluting or handling prior to use. Simply apply the reagents to your sample slide according to the protocol and you're steps away from obtaining high-quality IHC data.
| Product name | IHCeasy PHF1 Ready-To-Use IHC Kit |
| Sample type | FFPE tissue |
| Assay type | Immunohistochemistry |
| Primary antibody type | Rabbit Polyclonal |
| Secondary antibody type | Polymer-HRP-Goat anti-Rabbit |
| Reactivity | Human, Mouse, Rat |
Kit components
| Component | Size | Concentration |
|---|---|---|
| Antigen Retrieval Buffer | 100 mL | 50× |
| Washing Buffer | 100 mL ×2 | 20× |
| Blocking Buffer | 5 mL | RTU |
| Primary Antibody | 5 mL | RTU |
| Secondary Antibody | 5 mL | RTU |
| Chromogen Component A | 0.2 mL | RTU |
| Chromogen Component B | 4 mL | RTU |
| Signal Enhancer | 5 mL | RTU |
| Counter Staining Reagent | 5 mL | RTU |
| Mounting Media | 5 mL | RTU |
| Datasheet | 1 Copy | |
| Manual | 1 Copy |
Background Information
PHF1, also named as PHD finger protein 1, is a 567 amino acid protein, which contains 2 PHD-type zinc fingers and 1 Tudor domain and belongs to the Polycomblike family. Polycomb group (PcG) that specifically binds histone H3 trimethylated at 'Lys-36' (H3K36me3) and recruits the PRC2 complex. PHF1 Involve in DNA damage response and is recruited at double-strand breaks (DSBs). PHF1 acts by binding to H3K36me3, a mark for transcriptional activation, and recruiting the PRC2 complex: it is however unclear whether recruitment of the PRC2 complex to H3K36me3 leads to enhance or inhibit H3K27me3 methylation mediated by the PRC2 complex. According to some reports, PRC2 recruitment by PHF1 promotes H3K27me3 and subsequent gene silencing by inducing spreading of PRC2 and H3K27me3 into H3K36me3. According to another report, PHF1 recruits the PRC2 complex at double-strand breaks (DSBs) and inhibits the activity of PRC2. PHF1 regulates p53/TP53 stability and prolonges its turnover: PHF1 may act by specifically binding to a methylated from of p53/TP53.
Properties
| Storage Instructions | All the reagents are stored at 2-8°C. The kit is stable for 6 months from the date of receipt. |
| Synonyms | hPCl1, MTF2L2, PCL1, PHD finger protein 1, PHF1, PHF2, Polycomb like protein 1, Protein PHF1 |